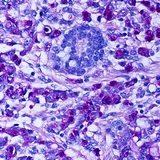

Nöroendokrin tümörlerde erken tanı hayati değerde
 İSTANBUL – Dünya Nöroendokrin Kanserleri Farkındalık Günü nedeniyle Nöroendokrin tümörler ile ilgili bir açıklama yapan Tıbbi Onkoloji Derneği Başkanı Prof. Dr. Şuayib Yalçın, nöroendokrin tümörlerin pek çok şekilde ortaya çıkabilen sinsi bir hastalık grubu olduğunu ve tanısında önemli gecikmeler yaşandığını belirtti.
İSTANBUL – Dünya Nöroendokrin Kanserleri Farkındalık Günü nedeniyle Nöroendokrin tümörler ile ilgili bir açıklama yapan Tıbbi Onkoloji Derneği Başkanı Prof. Dr. Şuayib Yalçın, nöroendokrin tümörlerin pek çok şekilde ortaya çıkabilen sinsi bir hastalık grubu olduğunu ve tanısında önemli gecikmeler yaşandığını belirtti.
 Hastaların yakınmaları ortaya çıktığında hekime erken dönemde gitmeleri gerektiğini dile getiren Prof. Dr. Yalçın, şu bilgileri verdi: “Nöroendokrin tümörlerde erken tanının hayati değere sahiptir. Şüphe etmezseniz, tespit edemezsiniz. Nöroendokrin kanserleri olan hastaların birçoğunda klinik belirtiler uzun sürede ortaya çıkmamaktadır. Belirtiler ortaya çıktığında ise hastanın dikkatini çekmeyebilir veya başka hastalıklarla karışabilmektedir. Birçok kez NET’ler başka bir hastalık nedeniyle yapılan tetkikler sırasında tanı almaktadır. Hastalık başlangıcından tanı konulana kadar geçen süre 5-7 yılı bulabilmektedir.”
Hastaların yakınmaları ortaya çıktığında hekime erken dönemde gitmeleri gerektiğini dile getiren Prof. Dr. Yalçın, şu bilgileri verdi: “Nöroendokrin tümörlerde erken tanının hayati değere sahiptir. Şüphe etmezseniz, tespit edemezsiniz. Nöroendokrin kanserleri olan hastaların birçoğunda klinik belirtiler uzun sürede ortaya çıkmamaktadır. Belirtiler ortaya çıktığında ise hastanın dikkatini çekmeyebilir veya başka hastalıklarla karışabilmektedir. Birçok kez NET’ler başka bir hastalık nedeniyle yapılan tetkikler sırasında tanı almaktadır. Hastalık başlangıcından tanı konulana kadar geçen süre 5-7 yılı bulabilmektedir.”
Erken tanı cerrahi operasyon şansı tanıyor
Nöroendokrin tümörlerin tedavisinde erken evrede tanı konulması durumunda en etkili tedavinin cerrahi olduğunu belirten Prof. Dr. Yalçın, şu bilgileri verdi: “Hastalar için ideal tedavi, tümör yayılmadan veya köken aldığı organ duvarını aşmadan önce cerrahi müdahaledir. Mümkün olduğunda, tümörün boyuna ve yerine göre, cerrahi müdahale ideal tedavi ve kesin iyileşme potansiyeli sunmaktadır. Erken tanı, tümörlerin büyüyüp başka organlara yayıldığı hallere kıyasla hastaya daha fazla tedavi seçeneği sunmaktadır. Başarılı tedavi ve yüksek yaşam kalitesi için erken tanı en önemli faktördür.”
 Nöroendokrin Tümör (NET) ile mücadele eden Dünya NET Örgütü, 2010 yılında 10 Kasım Günü’nü Dünya Nöroendokrin Kanserleri Farkındalık Günü olarak ilan etti. Erken tanı ve doğru tedavinin önemini vurgulamak amacı ile düzenlenen organizasyonlar ve toplantılar ile hastalar, hasta yakınları, sağlık hizmetleri uzmanları ve toplumun diğer üyelerinin, NET kanserleri hakkında bilgilendirilmesi, erken teşhisin önemi, doğru tedavi yöntemleri ve tedaviye erişimin gerekliliği konularında bilinçlendirilmesi amaçlanıyor.
Nöroendokrin Tümör (NET) ile mücadele eden Dünya NET Örgütü, 2010 yılında 10 Kasım Günü’nü Dünya Nöroendokrin Kanserleri Farkındalık Günü olarak ilan etti. Erken tanı ve doğru tedavinin önemini vurgulamak amacı ile düzenlenen organizasyonlar ve toplantılar ile hastalar, hasta yakınları, sağlık hizmetleri uzmanları ve toplumun diğer üyelerinin, NET kanserleri hakkında bilgilendirilmesi, erken teşhisin önemi, doğru tedavi yöntemleri ve tedaviye erişimin gerekliliği konularında bilinçlendirilmesi amaçlanıyor.
Dünya Nöroendokrin Tümörler Farkındalık günü bildirisi
Nöroendokrin tümörler (NET’ler) genellikle yavaş üreyen bir kanser türüdür ve tedavi edilmezlerse ciddi sonuçlara neden olabilirler. NET’ler geç evrede tanı konduğunda hastaların sağkalım şansı ve yaşam kalitesi üzerinde olumsuz etki yarattığı, NET hastalarının sağkalımı, sağlanan bakımın sürekli olması ve tedaviye erişim ile arttığı, NET’lerin tespiti ve tedavisindeki bilimsel ve tıbbi ilerlemeden tüm hastaların yeterince hızlı faydalanması için, zamanında tanı ve uygun tedavi ile NET’lerin tıbbi seyrinde ve yaşam kalitesinde anlamlı iyileşme sağlanabilmesi için, herkesi nöroendokrin tümör kanserlerine karşı bilinçli olmaya davet ediyoruz.
Nöroendokrin tümörler
 Nöroendokrin tümörler genellikle gastrointestinal sistemde ve akciğerlerde bulunan ve yavaş büyüyen tümörlerdir. Bunların çoğu diğer kanserlere kıyasla çok yavaş büyüdüğünden, genellikle ölçülebilir boyuta gelmeleri ya da belirtilere neden olmaları yıllar sürer. NET’lerin çoğu çok yavaş seyirli kanserdir. Ancak bazıları çok daha hızlı büyüme potansiyeline sahiptir. NET’ler birçok kez başlangıçta hasta ve hekim tarafından fark edilememekte ve başka hastalıklarla karışabilmektedir.
Nöroendokrin tümörler genellikle gastrointestinal sistemde ve akciğerlerde bulunan ve yavaş büyüyen tümörlerdir. Bunların çoğu diğer kanserlere kıyasla çok yavaş büyüdüğünden, genellikle ölçülebilir boyuta gelmeleri ya da belirtilere neden olmaları yıllar sürer. NET’lerin çoğu çok yavaş seyirli kanserdir. Ancak bazıları çok daha hızlı büyüme potansiyeline sahiptir. NET’ler birçok kez başlangıçta hasta ve hekim tarafından fark edilememekte ve başka hastalıklarla karışabilmektedir.
Nöroendokrin tümörlerin erken teşhisi tedavi için çok önemli
Belirtilerin ilk ortaya çıkışından tanı konmasına kadar çok uzun süre geçebilmektedir.
Nöroendokrin tümörler arasında karsinoid tümörler, insülinoma, gastrinoma, VIPoma, glukagonoma ve somatostatinoma gibi salgıladıkları maddelere bağlı belirti verebilen veya nonfonksiyone diye isimlendirilen belirti üreten madde salgılamayan tümörler yer almaktadır.
NET’ler yavaş büyüyen tümörlerdir ve vücudun diğer kısımlarına yayılmayabilirler. Kötü huylu olan NET’ler sıklıkla karaciğer, akciğer veya kemik veya batın içi lenf nodları, karın boşluğu ve karın zarına metastaz yapabilmektedir.
 NET’lerin ve karsinoid sendromun en yaygın semptomları karın ağrısı, sıcak basması, diyare, hırıltı, kronik öksürük, nüks eden akciğer enfeksiyonları, gaz, kalp çarpıntısı, deri döküntüsü, mide yanması ve kilo değişiklikleridir. Karsinoid sendrom, gastrointestinal nöroendokrin tümörlerden aşırı hormon salımı ile ilişkilendirilmektedir. Genellikle tümör karaciğere veya diğer bölgelere yayıldığında görülür. Karsinoid kanser hastalarının %20’sinde karsinoid sendrom görülür. Nöroendokrin kanserlerin tanısı ve izlenmesi için nükleer tıbbi görüntüleme ve biyokimyasal testler (kan, idrar, doku) kullanılmaktadır. Hastalığın tanı ve takibinde yararlı olabilecek başlıca testler şunlardır: kromogranin A (CgA), idrar 5-hidroksi indol asetik asit (5-HIAA), somatostatin reseptör görüntülemesi, bilgisayarlı tomografi, manyetik rezonans görüntüleme ve ultrason.
NET’lerin ve karsinoid sendromun en yaygın semptomları karın ağrısı, sıcak basması, diyare, hırıltı, kronik öksürük, nüks eden akciğer enfeksiyonları, gaz, kalp çarpıntısı, deri döküntüsü, mide yanması ve kilo değişiklikleridir. Karsinoid sendrom, gastrointestinal nöroendokrin tümörlerden aşırı hormon salımı ile ilişkilendirilmektedir. Genellikle tümör karaciğere veya diğer bölgelere yayıldığında görülür. Karsinoid kanser hastalarının %20’sinde karsinoid sendrom görülür. Nöroendokrin kanserlerin tanısı ve izlenmesi için nükleer tıbbi görüntüleme ve biyokimyasal testler (kan, idrar, doku) kullanılmaktadır. Hastalığın tanı ve takibinde yararlı olabilecek başlıca testler şunlardır: kromogranin A (CgA), idrar 5-hidroksi indol asetik asit (5-HIAA), somatostatin reseptör görüntülemesi, bilgisayarlı tomografi, manyetik rezonans görüntüleme ve ultrason.
YAZIYI PAYLAŞ

İSTANBUL – Dünya Nöroendokrin Kanserleri Farkındalık Günü nedeniyle Nöroendokrin tümörler ile ilgili bir açıklama yapan Tıbbi Onkoloji Derneği Başkanı Prof. Dr. Şuayib Yalçın, nöroendokrin tümörlerin pek çok şekilde ortaya çıkabilen sinsi bir hastalık grubu olduğunu ve tanısında önemli gecikmeler yaşandığını belirtti.
İSTANBUL – Dünya Nöroendokrin Kanserleri Farkındalık Günü nedeniyle Nöroendokrin tümörler ile ilgili bir açıklama yapan Tıbbi Onkoloji Derneği Başkanı Prof. Dr. Şuayib Yalçın, nöroendokrin tümörlerin pek çok şekilde ortaya çıkabilen sinsi bir hastalık grubu olduğunu ve tanısında önemli gecikmeler yaşandığını belirtti. Nöroendokrin tümörlerin erken teşhisi tedavi için çok önemli
Nöroendokrin tümörlerin erken teşhisi tedavi için çok önemli Kadınlarda ve erkeklerde en sık görülen kanser türleri ve tedavileri
Kadınlarda ve erkeklerde en sık görülen kanser türleri ve tedavileri Nöroendokrin tümörlerde ilk biyolojik tedavi
Nöroendokrin tümörlerde ilk biyolojik tedavi Sağlık Bakanlığı Döner Sermaye Yönetmeliği değişti
Sağlık Bakanlığı Döner Sermaye Yönetmeliği değişti Sutent, pankreas nöroendokrin tümörleri için Türkiye’de de onayladı
Sutent, pankreas nöroendokrin tümörleri için Türkiye’de de onayladı
YORUMUNUZ VAR MI?
Merhaba 30 yaşındayım bundan 2 yıl önce nöroendokrin mide tümörü teşhisi kondu .Metazlaz yok her 3 ayda endoskopi takibi önerildihenüz yaşım genç diye .İyi huylu diyolar fakat kötüye de çevirebilir dediler.Acaba ne yapmalıyım.Teşekürler
annem neroendekrin tümörüne 2003 de yakalanmıştı o yıl ameliyatla kurtuldu(pankreasın gövdesi,karaciğer,dalak,safra kesesi alınmıştı) ancak 2012 yılında tam 10 yıl sonra tekrar nüksettiği söylendi bu yılda yine ileçekal bölgede aynı yerde hemen 2. bir tümör olasılığının olduğunu söylediler çok üzgünüm neroendekrin üzerine uzmanlaşmış önerebileceğiniz kişiler varmı annemi kaybetmek istemiyorum isviçremi daha… Devamını oku »